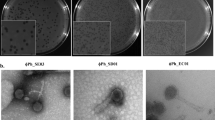

Abstract
COLICINE H, which kills many Escherichia, Shigella, Salmonella and a few Proteus hauseri1 also attacks many strains of P. morganii2. The relationship between P. morganii and the other genera mentioned has recently been strengthened by the finding3 that the guanidine + cytosine content of their deoxyribonucleic acids are very similar and differ from P. hauseri, P. rettgeri and Providence strains. On the other hand, it has been shown4,5 that although P. morganii strains are not susceptible to P. rettgeri phages, many P. morganii organisms are attacked by P. hauseri and Providence phages. There is also a well-known antigenic relationship between Proteus morganii and P. hauseri. Work on P. morganii phages has been confined to temperate varieties, and host-range determinations were limited to the Proteus group of organisms2,6. The phages were found to be species specific. In view of the uncertainty7 about the taxonomic position of Proteus morganii, it was decided to investigate the action of P. morganii phages derived from both lysogenic strains and sewage on members of the family Enterobacteriaceae.
This is a preview of subscription content, access via your institution
Access options
Subscribe to this journal
Receive 51 print issues and online access
$199.00 per year
only $3.90 per issue
Buy this article
- Purchase on SpringerLink
- Instant access to the full article PDF.
USD 39.95
Prices may be subject to local taxes which are calculated during checkout
Similar content being viewed by others
References
Fredericq, P., Rev. Belge Path. Med. Exp., 19, Supp., 4 (1948).
Vieu, J. F., Ann. Inst. Pasteur, 98, 416 (1960).
Falkow, S., Ryman, I. R., and Washington, O., J. Bact., 83, 1318 (1962).
Coetzee, J. N., Nature, 197, 515 (1963).
Coetzee, J. N., J. Gen. Microbiol., 31, 219 (1963).
Taubeneck, U., Zbl. Bakt. I. Abt. Orig., 185, 416 (1962).
Rauss, K., Int. Bull. Bact. Nom. Tax., 12, 53 (1962).
Rauss, K., Zbl. Bakt., I. Abt. Orig., 170, 428 (1958).
Stocker, B. A. D., J. Gen. Microbiol., 12, 375 (1955).
Author information
Authors and Affiliations
Rights and permissions
About this article
Cite this article
COETZEE, J. Host-range of Proteus morganii Bacteriophages. Nature 199, 827–828 (1963). https://doi.org/10.1038/199827b0
Issue date:
DOI: https://doi.org/10.1038/199827b0